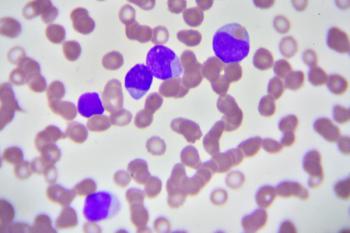

Researchers suggested that the use of the oral agent over a prolonged period of time should now be considered part of the overall treatment plan in acute promyelocytic leukemia.

Your AI-Trained Oncology Knowledge Connection!

Researchers suggested that the use of the oral agent over a prolonged period of time should now be considered part of the overall treatment plan in acute promyelocytic leukemia.

The chronic lymphocytic leukemia expert spoke about the possible use of venetoclax plus dose-adjusted R-EPOCH in various hematologic patient populations.

The expert discussed study methods from the NRG Oncology/Gynecologic Oncology Group (GOG) study presented at the 2020 ASCO Virtual Program.

Findings suggested that conventional mammography screening performance metrics underestimate the interval cancer rate of a mammography screening episode.

At the 2020 ASCO Virtual Program, Jun J. Mao, MD, MSCE, presented a study designed to evaluate the comparative effectiveness of electro-acupuncture and auricular acupuncture versus usual care in managing pain in cancer survivors.

Data from the registry suggested that in patients with cancer and COVID-19, cancer that is progressing was independently associated with an increased risk of death.

Researchers found that dense allele-specific DNA methylation (ASM) mapping in normal samples plus cancer samples reveals possible candidate regulatory sequence polymorphisms (rSNPS) that are difficult to find by other approaches.

The FDA accepted and granted priority review to a supplemental biologics license application for pembrolizumab as monotherapy for the treatment of adult patients with relapsed or refractory classical Hodgkin lymphoma.

The president and CEO of Cancer Treatment Centers of America highlighted the importance in caring for patients with cancer even in the midst of the coronavirus disease 2019 (COVID-19) pandemic.

The expert explained how states that expanded Medicaid coverage saw a steeper decline in cancer mortality rates, and next steps for further evaluation.

Merck and Eisai announced that the FDA issued a complete response letter to its accelerated approval applications for the combination use of pembrolizumab plus lenvatinib to treat patients with unresectable hepatocellular carcinoma.

At the 2020 ASCO Virtual Program, Courtney DiNardo, MD, presented on a study of the combination therapy consisting of ivosenidib plus venetoclax with or without azacytidine patients with IDH1-mutated acute myeloid leukemia.

In this study, researchers observed no association between black race and the risk of SREs and overall mortality in men with bone metastatic castration-resistant prostate cancer.

In this study, neutrophil extracellular traps were found to prompt the lethal blood clots and inflammation that occur in some patients with COVID-19.

At the 2020 ASCO Virtual Scientific Program, Karen H. Lu, MD, presented on findings from the MAGENTA trial, designed to test whether pre and/or post-test genetic counseling is needed to optimally deliver online accessible genetic testing.

The phase 3 ASCENT trial designed to evaluate sacituzumab govitecan-hziy in patients with brain metastasis-negative, metastatic triple-negative breast cancer met its primary end point of progression-free survival.

The FDA lifted the partial clinical hold on the on the pivotal phase 2 trial of camidanlumab tesirine (Cami) – designed to evaluate the antibody drug conjugate in patients with relapsed or refractory Hodgkin lymphoma.

The expert oncologist discussed the findings of the COVID-19 and Cancer Consortium and how the results of the consortium should inform conversations with patients with cancer.

The study of temsirolimus and cetuximab versus temsirolimus alone in patients with recurrent or metastatic cetuximab-resistant head and neck cancer did not meet its primary end point of improved progression-free survival.

Patients with chemotherapy-naïve, locally advanced, or metastatic non-small cell lung cancer who were treated with tiragolumab plus an anti-PD-L1 agent showed better efficacy versus single-agent checkpoint inhibitor therapy alone.

This study found that Hispanic adults trust a wide variety of health information sources, indicating the need for targeted and tailored information from healthcare providers.

However, when followed by immunomodulatory drugs, researchers found that autologous stem cell transplant can be safely used in this patient population, regardless of CHIP status.

Results of phase 3 CONDOR study could have a far-reaching impact on patients with prostate cancer.

The findings support ctDNA testing in patients who are undergenotyped at the time of diagnosis and as a primary option at the time of progression on targeted therapies.

In this open-label, randomized, phase 2 trial, treatment with trastuzumab deruxtecan led to significant improvements in response and overall survival in patients with HER2-positive gastric cancer.

Fam-trastuzumab deruxtecan-nxki (Enhertu) showed favorable clinical activity with a high objective response rate and durable responses in patients with HER2-mutated non-small cell lung cancer.

The University of Southern California expert discusses next steps for the trial and how the recent results could impact the future of care for patients with prostate cancer.

The study demonstrated modest survival benefits in patients with extensive-stage small cell lung cancer who received the combination of pembrolizumab and etoposide plus platinum (EP).

Researchers have developed a new blood test that may help in identifying individuals who are likely to develop hepatocellular carcinoma.

Results showed that once daily relugolix established superiority over leuprolide and reduced the incidence of major cardiovascular events.